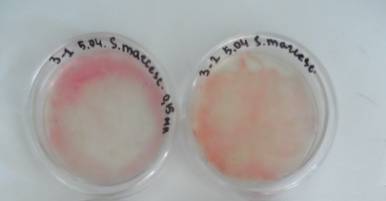
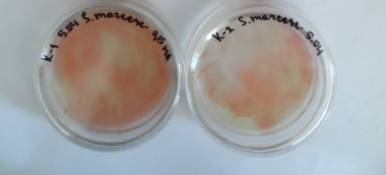

Біологічні
науки/6. Мікробіологія
Новіченко В.Г., д.б.н. Рильський О.Ф.
Запорізький національний університет, Україна
ВПЛИВ
ВОДИ «ЗДОРОВ'Я» НА РІСТ БАКТЕРІЙ BACILLUS
SUBTILIS ТА ПІГМЕНТСИНТЕЗУВАЛЬНУ ЗДАТНІСТЬ SERRATIA
MАRCESCENS
ВСТУП. Відомо, що серед всього
різноманіття рослинного та тваринного світу немає жодної істоти, плоть якої не
складалася би більше, ніж на половину з води. Організм людини не є виключенням.
Цей факт є вагомим аргументом, щоб, як мінімум, передбачати, що здоров’я
безпосередньо залежить від якості води, яку вживає людина.
На даний час чистої
природної води в нашій країні немає або практично немає, а якщо зважати на
вищевказані факти статистики, то сьогодні необхідна не тільки якісна вода для
щоденного вжитку, але й вода з активними оздоровчими властивостями [1, 2].
Огляд існуюючих на
сьогодні методів активації води дозволив зробити висновок, що одними з найбільш
ефективних і економічних для технологічного втілення методів надання воді
особливих властивостей є активація води магнітним полем та вортексний метод [3,
4].
Активація води – це
процес перерозподілу властивого воді потенціалу для посилення одних її
властивостей за рахунок послаблення інших.
У Запорізькому
профілактико-оздоровчому центрі «Здоров’я» була отримана активована вода (в
подальшому вода «Здоров’я»), за допомогою якої можливо впливати на широкий
спектр біологічних процесів.
Метою нашого
дослідження було вивчення кривих
зростання бактерій на м’ясопептонному бульйоні (МПБ), приготованому на воді з
центру «Здоров’я», та порівняння з кривими зростання бактерій, вирощених на МПБ,
приготованому на водопровідній воді. А також дослідження впливу активованої
води на пігментосинтезувальну здатність бактерій.
МАТЕРІАЛИ ТА МЕТОДИ ДОСЛІДЖЕННЯ. Предметом дослідження був вплив води «Здоров’я» на ріст бактерій Bacillus subtilis та пігментосинтезувальну
здатність Serratia mаrcescens.
Об’єктами
дослідження були пігментосинтезувальні бактерії S. marcescens та
пробіотична культура Bacillus subtilis з колекції відділу мікробіології очищення води Інституту колоїдної хімії
та хімії води НАН України. Культивуваня проводили на рідкому поживному
середовищі – МПБ і твердому – м’ясопептонному агарі (МПА), приготованих на
трьох різних водах: дистильованій, водопровідній та на воді «Здоров’я»
(дослід).
МПБ готували з
використанням 250 мл досліджуваної води «Здоров’я», яку нагрівали лише до 60 0С, тому
що дана вода за вищої температури може втратити свої властивості. Контролем
слугував МПБ, приготований за загально прийнятою методикою на дистильованій
воді (також 250 мл). Культуру
B. subtilis вносили до поживного
середовища по 3 мл суспензії щільністю 106 клітин на 1 мл. Швидкість зростання культури в досліді і
контролі порівнювали через побудову кривої зростання на дослідному і контрольному
МПБ. Культивування проводили при 29 0С з використанням слабкої
примусової аерації. Оптичну щільність культуральної рідини вимірювали за
допомогою фотоелектроколориметру КФК-2 при довжині хвилі 540 нм.
Були також зроблені
виміри таких показників як окисно-відновний потенціал (ОВП) та рН досліджуваної
води «Здоров’я» та водопровідної води перед початком досліду.
Дослідження
інтенсивності пігментоутворення у S.
marcescens при зростанні на МПА, приготовленому на 2-х водах (водопровідній
та на воді «Здоров’я»), проводили за допомогою пакета програм СІЕ Lab у
програмі Adobe Photoshop шляхом оцінки кольору цифрового зображення.
Культуру S. marcescens засівали по 0,15 мл
суспензії щільністю 108 клітин на 1 мл методом Дригальского по 3
чашки Петрі із застиглим середовищем МПА. Дослідні зразки культивували протягом
3-х днів у термостаті при температурі 29 0С. Контролем слугувала
культура пігментосинтезувальної бактерії S.
marcescens, яка була вирощена на
твердому поживному середовищі МПА в чашках Петрі, приготованому на водопровідній
воді.
На третю добу зразки культур бактерій фотографували, передавали
цифрове зображення на комп'ютер в програму Adobe Photoshop, після чого за
допомогою пакета програм СІЕ Lab визначили відтінки для кожного первинного
кольору, порівнювали колір вирощених культур бактерій, обумовлений
інтенсивністю пігментоутворюючої активності бактерій дослідного та контрольних
зразків, і за різницею між кольорами (dE) визначили зміну інтенсивності пігментоутворення [5].
ЕКСПЕРИМЕНТАЛЬНА ЧАСТИНА. Виміри
показників ОВП та рН досліджуваної та водопровідної води перед початком досліду
представлені в табл. 1. Встановлено, що значення першої і другої води не
виходять за традиційні інтервали для питної водопровідної води [6].
Таблиця
1
ОВП
та рН досліджуваної води
|
Показники |
Вода
"Здоров'я" |
Водопр. вода |
|
ОВП, мВ |
+ 224 |
+ 226,6 |
|
рН |
7,96 |
7,66 |
Результати
дослідження впливу води «Здоров’я» на ріст культур
B. subtilis і S. mаrcescens представлені на рис. 1 і 2.

Рис. 1. Відмінності
інтенсивності росту B. subtilis на
поживному середовищі МПБ, приготованому на різній воді

Рис. 2. Відмінності інтенсивності
росту S. mаrcescens на поживному
середовищі МПБ, приготовленому на різній воді
З графіків видно, що
lоg-фаза у культури B. subtilis, що зростає на воді «Здоров’я»
(рис. 1), протікає значно активніше. На 22 годину культивування різниця у
кількості клітин в середовищі між дослідом і контролем складає 0,5 одн.
оптичної щільності. Така різниця вказує на те, що клітини в дослідному варіанті
значно швидше діляться, ніж в контролі.
У культури S. mаrcescens, яка зростає на МПБ,
приготованому на воді «Здоров’я» (рис. 2), lag-фаза коротша (3 години в досліді і 4 години в контролі), а також більш
активний початок lоg-фази. Це може свідчити про те, що ферментативні системи
клітин на цій воді значно активніше перебудовуються під нове поживне
середовище.
Така різниця в
lag-фазі і lоg-фазі в обох культур при зростанні на МПБ, приготованому на дослідній
воді «Здоров’я», свідчить про наявність стимулюючого ефекту на ріст бактеріальних
клітин.
Результати
дослідження впливу води «Здоров’я» на пігментосинтезувальну здатність S. mаrcescens представлені в табл. 2 та на
рис. 3.

Рис. 3. Пігментсинтезуюча
здатність Serratia marcescens на
середовищі МПА, приготованому на різній воді
Примітка: З-1, З-2 – МПА на водопровідній воді; К-1, К-2 –.МПА на воді «Здоров’я».
Візуальний аналіз
інтенсивності забарвлення культури S. mаrcescens, а також аналіз за
допомогою програми Adobe Photoshop показали, що інтенсивність пігментоутворення
у S. mаrcescens при зростанні на МПА,
приготовленому на воді «Здоров’я», вище ніж в контролі (МПА на дистильованій та
водопровідній воді), і різниця в інтенсивності кольору між дослідом і контролем
коливається від 13,9 до 17,6 одиниці (табл. 2).
Таблиця
2
Оцінка
інтенсивності пігментоутворення S.
marcescens на МПА, приготовленого на різній воді
|
Показники каналів кольорової моделі СІЕ
Lab |
dE |
|||||
|
МПА на дист. воді |
МПА на воді «Здоров’я»
|
17,6 |
||||
|
L |
a |
b |
L |
a |
b |
|
|
43 |
39 |
16 |
57 |
17 |
14 |
|
|
МПА на водопр. воді |
МПА на воді «Здоров’я»
|
13,9 |
||||
|
L |
a |
b |
L |
a |
b |
|
|
46 |
20 |
24 |
52 |
24 |
7 |
|
ВИСНОВКИ.
1. Результати проведених дослідів показують, що вода «Здоров’я» володіє
стимулюючим ефектом як по відношенню до грамнегативної культури
S. marcescens, так і до грампозитивної
B. subtilis при культивуванні
бактерій в рідкому поживному середовищі.
2. Інтенсивність пігментоутворення у S.
marcescens при зростанні на МПА, приготовленому на воді «Здоров’я», також
вища, ніж при зростанні на МПА, приготовленому на водопроводній та
дистильованій воді.
ЛІТЕРАТУРА.
1. Гвоздяк П.І. Біологічні аномалії води, або чотири запитання для обміркування
/ П.І. Гвоздяк // Вісник НАН України. – 2005. – № 4. – С. 45-52.
2. Гвоздяк П.І. Біохімія води як перспективний науковий напрям
/ П.І. Гвоздяк // Вісник НАН України. – 2006. – № 9. – С. 21-23.
3. Новиченко В.Г. Жизнь
воды / В.Г. Новиченко, С.В. Шеховцов. – Киев: Фитосоциоцентр, 2010. – 191 с.
4. Бердышев Г.Д. Изотопика воды / Г.Д. Бердышев, В.Г. Новиченко. – Киев: Фитосоциоцентр,
2009. – 192 с.
5. Пат. України № 49812, МПК (2009), С12Q 1/00, С12М 1/00, С12М 1/34. Спосіб визначення інтенсивності
пігментоутворення у бактерій / Рильський О.Ф., Домбровський К.О., Гороховський
Є.Ю., Жиленко А.В.; заявник і патентовласник Запорізький національний
університет; заявл. 30.11.2009; опубл. 11.05.2010. – Бюл. № 9, 2010 р.
6. Ашбах
Д. Живая и мертвая вода против свободных радикалов и старения: народная
медицина, нетрадиционные методы / Д. Ашбах. – Москва: Астрель, 2011. – 119 с.